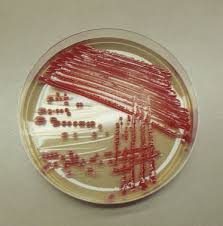
مانیتول

فرمول ملکولی: C12H24O11
معرفی محصول:
- طعم طبیعی و خالص شکر، ایزومالتیتول به عنوان بهترین تعدیل کننده طعم نامطبوع سایر شیرین کننده ها مورد استفاده قرار می گیرد.
- استفاده از ایزو مالتیتول در مواد غذایی مانع از پوسیدگی دندان ها می شود.
- استفاده از ایزومالتیتول در مواد غذایی برای مصرف بیماران دیابتی بسیار مفیدتر است.
- ایزومالتیتول در واکنش های شیمیایی با سایر مواد اولیه بسیار پایدار تر است. برای مثال واکنش میلارد بین ایزومالتیتول و آمینو اسید ها رخ نمی دهد.
- ایزومالتیتول توسط میکروارگانیسم ها تجزیه نمی شود. بنابراین استفاده از ایزومالتیتول در صنایع غذایی بازه تاریخ مصرف محصولات را طولانی تر می کند.
- کنفرانس کارشناسی متشکل از FAO/WHO در زمینه افزودنیهای مواد غذایی (JECFA) محدودیتی برای مصرف روزانه ایزومالتیتول در نظر نگرفته است. کارخانجات تولد مواد غذایی به طور گسترده ای از ایزومالتیتول در تولید غذاهای بدون شکر و رژیمی استفاده می کنند.
ویژگی ها:گرانول 20-40/ پودر 160-200
|
Appearance |
Whitecrystal powder |
|
GPS+GPM-Content |
98%-102% of which 43-57% is GPS |
|
Water(free and crystal) |
≤7.0% |
|
D-mannitol |
≤0.5% |
|
D-sorbitol Redoing sugars(as glucose) |
≤0.5% ≤0.3% |
|
Ash content |
≤0.05% |
|
Total heavy metal(as lead) |
≤10mg/kg |
|
Arsenic |
≤0.2mg/kg |
|
Lead |
≤0.3mg/kg |
|
Nickel |
≤2mg/kg |
|
Bacteria Bacleria q'ty |
≤500cfu/g |
|
Colon Bacillus Bacteria q'ty |
≤30MPN/g |
|
Causative organism (enterococcus and enter pathogenic bacteria) |
None |
|
Yeasts and noulds |
≤10cfu/g |
|
Additional parameters color of solution |
≤75ICUMSA units |
نوع بسته بندی: در کیسه و یا ظروف استوانه ای های 20 و 25 کیلوگرمی

معرفی محصول: (CP2005 / BP2007 / USP30) 80mesh, 120mesh, 300mesh
معرفی محصول: (CP2005 / BP2007 / USP30) 80mesh, 120mesh, 300mesh